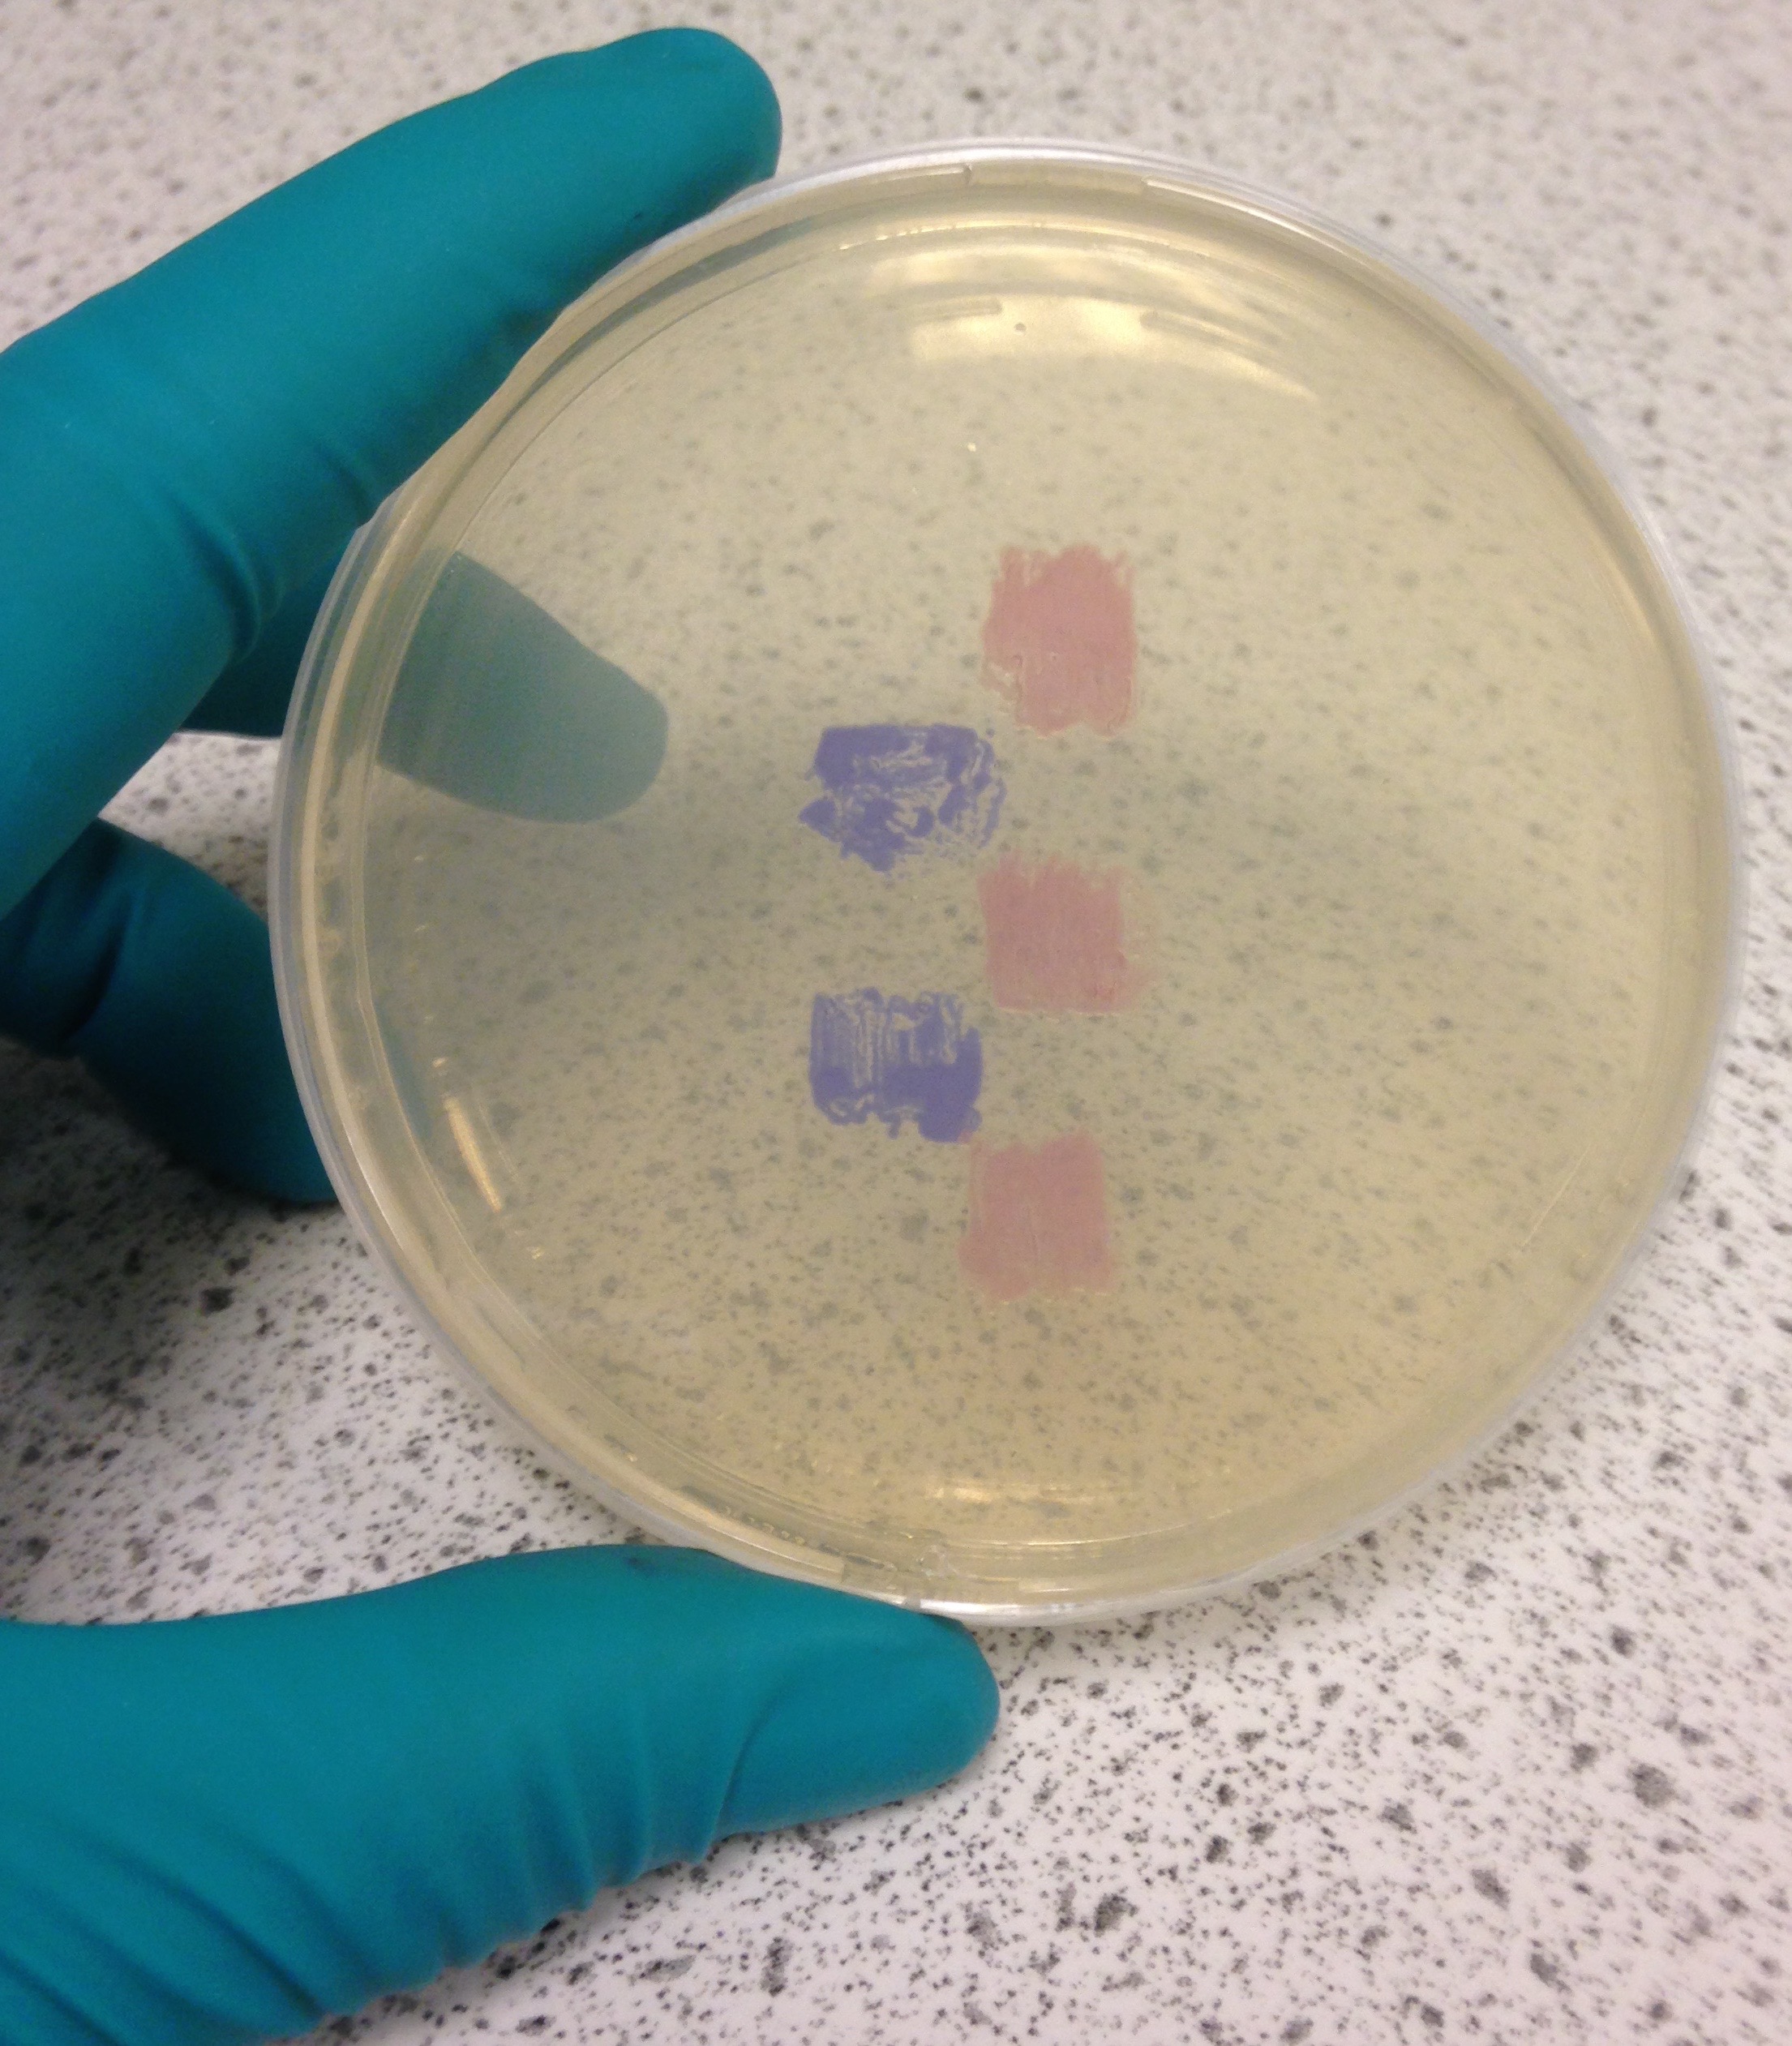

Matt Jones, PhD SFHEA

My research seeks to understand how plants perceive and respond to changes in their environment, with the ultimate goal of using this knowledge to promote stress tolerance in crop plants. To achieve this we are using traditional molecular biology techniques in combination with the latest advances in synthetic biology to manipulate how light signals are integrated into the circadian system.
A more detailed biography can be found here.
Martin Battle, PhD

As sessile photoautotrophs, plants are amongst the organisms most sensitive to, and influenced by, changes in their surrounding light conditions. Using photoreceptors found naturally in cyanobacteria we will engineer new light sensitive pathways in plants allowing for direct control of targeted genes using light as a trigger. Using this system we will examine the interactions between the plant circadian clock and genes involved in maintaining circadian rhythms.
Cathryn Dickson

Cathryn provides support to projects in the Jones lab.
Xinmeng Liu (PhD Student)

My research focuses on how specific components of the PAP signalling pathway can improve the drought resistance of wheat.
Scott Ewing (PhD Student)

My research focuses on using optimised light treatments and gene editing to manipulate the circadian clock to increase crop yield and quality in desirable species such as basil and kale. I’m interested in how light signals affect the mechanism of the circadian clock and when I’m not in the lab, you can usually find me enjoying the outdoors or watching a horror movie.
Chantal Sharples (PhD Student)

I've just started my PhD in the Jones lab.
Weiqi Liu (PhD Student)

I'm currently working on creating transgenic plants with constitutively-activated photoreceptors to understand how to increase crop performance in vertical farming.
Alumni
Suzanne Litthauer, PhD

My PhD research aimed to provide a glimpse into how plants adapt to stress occurring as a result of changes in their environment, and how these stress responses interlink with the circadian clock. Of particular interest to me was the role played by 5'-Phosphoadenosine 3'-Phosphate, which accumulates in plants under high light and heat stress. I was able to show that this metabolite delays the circadian system in response to osmotic stress. I also developed a novel method to measure circadian rhythms in vivo.
Marina Viana Queiroz, PhD

My research focus is the use of LED lights at storage to improve the post-harvest of kale leaf and minimally processed by increasing the shelf life and maintain the content of bioactive compounds, like phenolic compounds, anthocyanins and flavanols, that are beneficial to human health. As a good Brazilian, I never refuse a party or socializing! I like to meet people, new cultures, places.
Jingwen Yao, PhD

I was a Ph.D student of plant physiology, visiting the Jones lab from China. My PhD research focuses on the mechanism of melatonin affecting the photoperiod pathway of Arabidopsis. I am also interested in the effect of melatonin on plant physiological phenotype like stomata movement under circadian rhythm.
Emily Armstrong, PhD

My project looks at isoform switches at different times and temperatures, and how this controls circadian rhythms. I love big sequencing experiments, abiotic stress biology, improving accessibility in academia, and talking about science to public audiences. When I'm not in the lab I'm usually enjoying the outdoors, cooking for my flatmates, and have big plans to turn my tiny car into a camper van.
Mhairi Davidson, PhD

I’m working on a collaborative project with a company to optimise growth in vertical farms by manipulating lighting regimes. I enjoy learning new things like lab techniques, cooking recipes, and knitting snitches!
Franco Vegliani (PhD Student)

Franco worked to understand how drought response interacts with light reception by looking at how photoreceptor mutants' circadian period is affected by drought under different light qualities.
Putri Prasetyaningrum, PhD

I did my PhD in PlantLab-Sant’Anna School of Advanced Studies (Pisa - Italy) and graduated in March 2019. From the PhD project, I found that the integration of light, circadian clock and sugar signals resulted in rhythmicity of Gibberellin abundance and subsequently rosette growth rhythm. In the Jones Lab I investigated how osmotic stress altered circadian clock and post-transcriptional gene regulation.
Ellie Stallard (PhD Student)
I worked on my PhD at the University of Essex- my project was co-supervised by Prof. Phil Mullineaux.